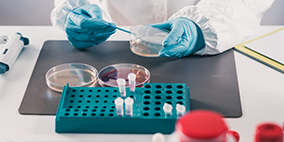
上海研鱼检测技术有限公司

关于我们

上海研鱼检测技术有限公司(简称“STS”)是一家专业从事检测、测试、技术咨询等服务的科创型技术企业。专业第三方检测技术服务平台,为全球范围内的企业及相关机构提供专业、公正、严谨的第三方检验检测及咨询服务。自成立以来,研鱼检测凭借守信创新、稳步发展,现已拥有一批长期从事检验、检测、咨询服务的技术精英,依托服务开拓市场的经营策略,深挖市场需求;研鱼检测主要从事杀灭(驱避)蚊虫害虫类检测,斑马鱼功效检测,提供国内外认证服务,食品化妆品检测,消毒产品检测、、毒理学检测、理化微生物检测、生态毒理与环境安全检测以及医药、医疗器械、成分分析、油品检测、高校科研等相关检测服务。
拥有强大的仪器平台和数据库,10余年行业经验的技术团队